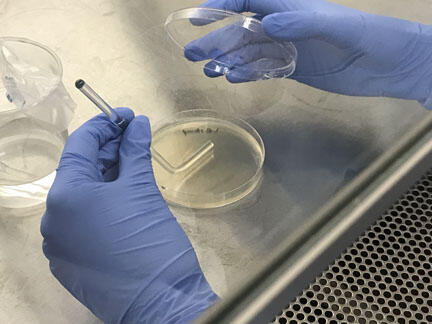
Spread plate procedure for quantitative culture Renibacterium salmoninarum

WFRC Quantitative Culture for Renibacterium salmoninarum Image 3

Detailed Description
Spread plate procedure for quantitative culture Renibacterium salmoninarum from fish tissue or ovarian fluid.
Sources/Usage
Public Domain.
Spread plate procedure for quantitative culture Renibacterium salmoninarum from fish tissue or ovarian fluid.
Public Domain.